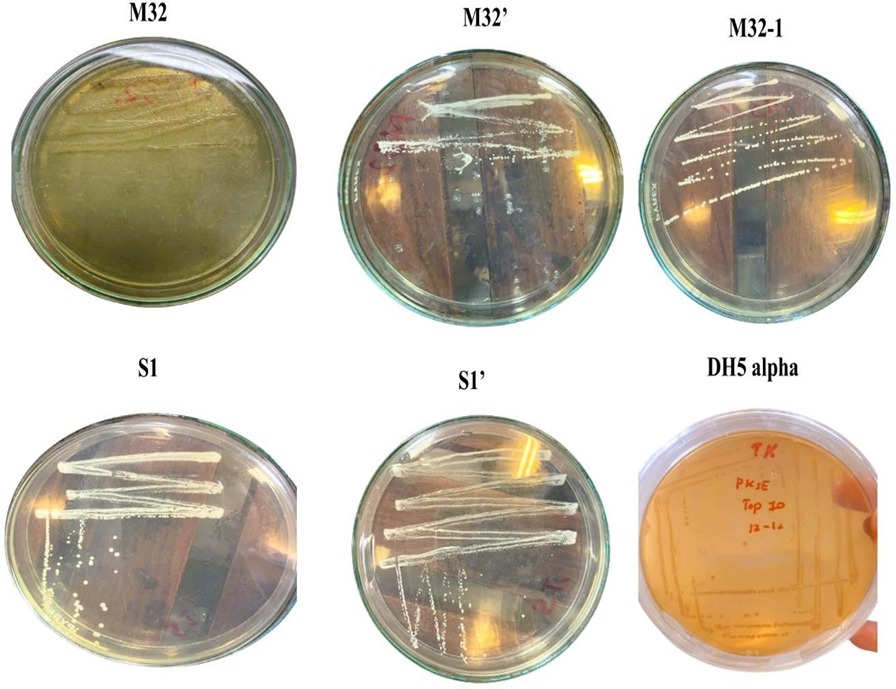
Image

Professional Summary
Highly motivated life sciences researcher with an MPhil in Zoology and robust expertise at the intersection of immunology, pharmacology, and toxicology. My foundational research leverages in vivo models to evaluate the complex physiological impacts of therapeutic compounds. I bring a multidisciplinary edge to scientific inquiry, combining collaborative experience in molecular biology (CRISPR-Cas) and microbiology with advanced technical proficiencies in Python, rigorous biostatistical analysis, and scientific visual communication. Driven by a commitment to advancing human and animal health, I am actively seeking a funded PhD position where I can apply my versatile skill set to investigate complex biological systems and contribute to impactful discoveries across the life sciences.
Featured Research Projects
Construction of Crispr-Cas9 Cassette for Bacterial Genome Insertion through Homologous Recombination

A Multifaceted Investigation of Differential and Synergistic Effects of Ginger and Garlic Essential Oils on Rabbit Growth, Liver Redox Activity, and Immunity
Academic Publications
Bridging the Gap Between Herbs and Pharmaceutics: The Science Behind Herbs’ Medicinal Properties and Potential in Modern Drugs
Revista Brasileira de Farmacognosia-Brazilian Journal of Pharmacognosy, (2025)
PublishedEthanolic Chicory Leaf Extract Enhances Hematological Profile, Gut Microbiota, and Intestinal Morphology in Rabbits
Open Veterinary Journal, (2026)
Accepted & In PressOfficial acceptance letter available upon request
Featured Coursework & Skills
Formal Degree Coursework
Advanced Physiology
MPhil Level Coursework
Hematology
MPhil Level Coursework
Proteomics
MPhil Level Coursework
Environmental Sciences
MPhil & MSc Level Coursework
Basic and Applied Biostatistics
MSc & MPhil Level Coursework
Cell and Molecular Biology
MSc Level Coursework
Microbiology
MSc Level Coursework
Applied Entomology
MSc Level Coursework
Awards & Honors

MSc Merit Certificate
Awarded 2024
Awarded for outstanding academic performance, rigorous laboratory work, and overall excellence.
Certificate Pending
MPhil Merit Award
2026 (Official Document Pending)
Recognized for exceptional research and academic achievements during my MPhil in Zoology.
Professional Certifications


.jpg)
.jpg)
.jpg)
.jpg)

.jpg)
.jpg)
.jpg)
My Journey So Far
Enrolled in Python programming course
Currently learning Python for data analysis in life sciences.
Research assistant
Laboratory of Animal physiology, Hematology & Immunology, Department of Zoology, University of Gujrat.
Ecommerce business owner & marketing manager
Marketing and selling of beauty products.
Course on Ecommerce and marketing strategy
To gain knowledge of brand development & selling products.
MPhil in Zoology
Conducted rigorous thesis research exploring mechanistic pathways.
Diploma in Graphic designing
Visual storytelling, branding, print and digital design solutions.
Worked as a Freelancer
Provided specialized scientific content writing services as an independent professional.
MSc in Zoology
Advanced study and research in animal cell & molecular; physiology, microbiology, bioinformatics, insect ecology, biostatistics and biochemistry.
Subject Teacher
Taught Biology & Chemistry in Dar-e-Arqam School Kharian.
BSc in Zoology, Botany & Psychology
Built a Strong foundation in biological and psychological sciences.
Professional Competencies
Let's Connect 👋
I am actively seeking doctoral positions in the biological sciences. I welcome inquiries regarding prospective PhD opportunities, research collaborations, or academic discussions.